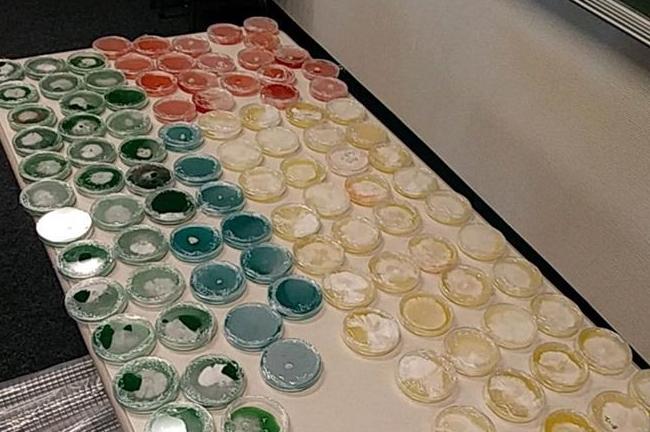
ISP - MAGIC MUSHROOM ARREST - 8-28-19.jpg

LOUISVILLE, Ky. (WDRB) -- Indiana State Police arrested a Charlestown, Indiana, couple who is accused of growing and selling psychedelic mushrooms.
Police said Jedidiah Lee Adams, 29, and Bailey Michelle Rutkowski, 31, were arrested Tuesday at their home on Woodridge Drive in Charlestown by ISP troopers who were acting on a tip of possible drug activity.
After their initial trip to the residence, troopers requested and were granted a search warrant by a Clark County judge, police said. As a result of further investigation of the property, police arrested and charged Adams and Rutkowski with Manufacturing and Dealing in a Schedule I Drug (psilocybin), Neglect of a Dependent, Possession of Marijuana and Possession of Paraphernalia.
Both Adams and Rutkowski are being held at Clark County Jail.
Copyright 2019 WDRB Media. All Rights Reserved.